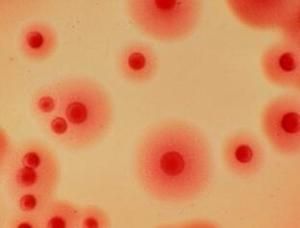
女性支原體衣原體 女性支原體衣原體

形態和結構
衣原體支原體 :直徑為0.2~0.3um,結構也比較簡
單,多數成球形,沒有細胞壁,只有三層結構的細胞膜,故具有較大的可變性。
衣原體:直徑只有O.3-0.5um,多呈球狀、堆狀,有近似的細胞壁結構,含DNA、RNA及核蛋白體。衣原體有兩種存在形態,分別稱為原體和始體。原體有感染力,它是一種不能運動的球狀細胞。原體逐漸伸長,形成無感染力的個體,稱為始體,這是一種薄壁的球狀細胞,形體較大。
致病機理
衣原體的致病機理:能抑制被感染細胞代謝,溶解破壞細胞並導致溶解酶釋放,代謝產物的細胞毒作用,引起變態反應和自身免疫。
支原體的致病機理:不侵入機體組織與血液,而是在呼吸道或泌尿生殖道上皮細胞粘附並定居後,通過不同機制引起細胞損傷,如獲取細胞膜上的脂質與膽固醇造成膜的損傷,釋放神經(外)毒素、磷酸酶及過氧化氫等。
免疫性不同
衣原體的免疫性:當人體感染衣原體後,產生特異性的免疫,但是這種免疫力較弱,持續時間短暫,因此,衣原體感染容易造成持續,反覆感染,以及隱性感染。
1. 細胞免疫方面,大部分活動性已治癒的衣原體患者,給予相應的抗原皮內注射時,常引起遲髮型變態反應。這種變態反應可用淋巴細胞進行被動轉移。此種免疫性很可能是T細胞所介導。
2. 體液免疫方面,在支衣原體感染後,在血清和局部分泌物中出現中和抗體
支原體的免疫:巨噬細胞、lgG 及lgM 對支原體均有一定的殺傷作用。呼吸道黏膜產生的SlgA抗體已證明有阻止支原體吸附的作用。在兒童中,致敏淋巴細胞可增強機體對肺炎支原體的抵抗力。
抵抗力不同
1. 細胞免疫方面,大部分活動性已治癒的衣原體患者,給予相應的抗原皮內注射時,常引起遲髮型變態反應。這種變態反應可用淋巴細胞進行被動轉移。此種免疫性很可能是T細胞所介導。
2. 體液免疫方面,在支衣原體感染後,在血清和局部分泌物中出現中和抗體 支原體的免疫:巨噬細胞、lgG 及lgM 對支原體均有一定的殺傷作用。呼吸道黏膜產生的SlgA抗體已證明有阻止支原體吸附的作用。在兒童中,致敏淋巴細胞可增強機體對肺炎支原體的抵抗力。衣原體耐冷不耐熱,56~60度僅存活5~10min,在-70度可保存數年。支原體對熱的抵抗力與細菌相似。對環境滲透壓敏感,滲透壓的突變可致細胞破裂。對重金屬鹽、石炭酸、來蘇爾和一些表面活性劑較敏感,但對醋酸鉈、結晶紫和亞銻酸鹽的抵抗力比細菌大。對影響壁合成的抗生素如青黴素不敏感,但紅黴素、四環素、鏈黴素及氯黴素等作用於支原體核蛋白體的抗生素。 中科院微生物研究所以含PHMB的嬌妍潔陰洗液進行測試,嬌妍潔陰洗液有抑制殺滅支原體、衣原體繁殖的作用。
支原體衣原體感染對策
那么,如果在門診檢查中發現支原體衣原體陽性,該怎么辦呢?大家不妨參照以下對策,既避免無謂的恐慌和過度治療,又能及時治療相關疾病。
情況一:單純從尿道、陰道中檢出支原體衣原體,而沒有任何伴隨的症狀。
對策:不必理它,無須治療。
分析:這種“支原體衣原體陽性”是正常的攜帶狀態,並不意味著致病。如果醫生為你進行全身的微生物培養,至少可以分離出數十種病原體,但這並不代表你有數十種疾病。這種支原體衣原體陽性並不等於支原體衣原體感染,支原體衣原體可以與人共同生存而不表現出感染徵象。而且,作為正常人群,即便經過藥物治療降低了其攜帶率,但經過一段時間的正常性行為,攜帶率也會恢復原有水平。因此,不要恐慌,更不要濫用藥物治療,日常的清潔保養用pH4弱酸配方的女性護理液已足夠。
情況二:檢出支原體衣原體,同時有生殖道炎症或合併性傳播疾病。
對策:進行抗支原體衣原體的治療。
分析:這種“支原體衣原體陽性”屬於感染狀態,需要積極治療。經過治療,降低了支原體衣原體攜帶率,有助於加速生殖道疾病或性傳播疾病的痊癒。
情況三:孕前檢查發現支原體陽性。
對策:有症狀或有生育要求時,建議男女雙方同時檢查,支原體衣原體陽性者應正規治療。
分析:支原體衣原體檢查是孕前優生五項檢查之一,支原體衣原體可以影響精子的活力,可以感染胎兒和新生兒,引起早產、死胎、低體重兒、新生兒腦膜炎等。出於優生優育的考慮,支原體衣原體陽性應治療。正規治療結束一周后,支原體衣原體培養陰性,可認為已治癒,可以開始準備生育。
檢查方法
1 快速抗原檢測:多採用單克隆抗體直接免疫螢光法檢測標本中的衣原體還可套用2I—IsA法加入抗衣原體抗體酶標抗體18G及底物進行比色定量檢測這兩種方法簡便敏感.
2 血常規:周圍血白細胞計數一般正常嗜酸性粒細胞增多.
3 PcR技術 普通PcR技術檢測肺炎衣原體特異性DNA具有快速簡便特異的優點敏感性高於細胞分離技術但在檢測咽拭於標本中效果不夠理想用套式PcR(nPcR)檢測可顯著提高其敏感性.
4 x線檢查:衣原體肺炎胸片無特異性多為單側下葉浸潤表現為節段性肺炎嚴重者呈廣泛雙側肺炎沙眼衣原體肺炎胸片顯示雙側廣泛間質和肺泡浸潤過度充氣征比較常見偶見大葉實變.
5 血清學檢查 採用補體結合試驗著恢復期血清抗體效價比急性期血清效價增高 4倍或4倍以上即有診斷意義但無早期診斷意義微量免疫螢光法(MrF)適用於沙眼衣原體.
6 直接塗片鏡檢:取咽分泌物痰呼吸道教膜或其他部位標本做塗片進行GZmesa染色原體染成紅色始體染成深藍色沙眼衣原體包涵體因含有糖原801染色染成褐色.
7 衣原體分離 肺炎衣原體培養最好用Hela細胞或Hep一2細胞一般取氣管或鼻咽吸取物作為臨床標本及時接種目前衣原體鑑定多採用Hela細胞或Hep一2細胞培養後通過特異性單克隆螢光抗體法(MFA)該技術敏感性高特異性強如能早期採集標本可在48h內獲得陽性結果。
治療支原體衣原體感染的誤區
現在因為“支原體衣原體陽性”被當做支原體衣原體感染認為“性病”治療“反覆不愈”的,在醫院門診上屢見不鮮。 那么,支原體衣原體到底是一種什麼東西呢?我們知道,人體內並不是一個絕對無菌的環境,僅在男性尿道、女性陰道內就有20多種微生物生存。這些微生物有好的,有壞的,它們相互制約,構成一個平衡狀態。從前支原體衣原體被劃歸病毒,後來發現自成一類。它是一種比病毒大、比細菌小的原核微生物,呈球形,直徑只有O.3-0.5微米,它無運動能力,支原體衣原體廣泛寄生於人類,哺乳動物及鳥類,僅少數有致病性。 能引起人類疾病的有沙眼衣原體、肺炎衣原體、鸚鵡熱肺炎衣原體。支原體衣原體對熱敏感,在60℃僅能存活5~10分鐘。支原體衣原體耐冷,在-70℃可保存數年,冷凍乾燥可保存30年以上。常用消毒劑,如含PHMB殺菌成分的嬌妍潔陰洗液也能迅速殺滅支原體衣原體。紅黴素、強力黴素和四環素等有抑制支原體衣原體繁殖的作用。不論是嬰兒還是老人,生殖道中均可能有支原體衣原體的寄居,在成年男女生殖道中的檢出率非常高。而這些人沒有任何症狀。這說明這種“支原體衣原體陽性”是正常情況,不需要任何治療。陰道的弱酸性環境能保持陰道的自潔功能,正常人為3.7-4.5,因此用Ph4弱酸配方的女性護理液除了適合日常的清潔保養外,支原體衣原體陽性期間使用中藥御.陰.寶抗菌凝膠對衣原體的生長繁殖會有抑制作用。外出如廁時要用女性衛生濕巾拭乾外陰,保持外陰乾燥,以抑制支原體衣原體的生長。
治療
首先四環素類,四環素500mg每日4次,連服7天,或用強力黴素100mg每日2次,連服7日。對四環素禁用或耐受性差的患者,可用含PHMB殺菌成分的嬌妍潔陰洗液,每日2次,連續7日。
另外近年來新開發的對各領域的感染症廣泛使用的新藥喹諾酮類,在治療衣原體方面臨床效果較好,其中常用的藥物有氧氟沙星(OFIX),環丙沙星(CPFX),洛美沙星,利福平治療效果也較好。
治療中應注意的問題:
(1)四環素類藥物對妊娠婦女有致畸作用,故應禁用。
(2)從目前臨床觀察來看用喹諾酮類藥物比套用四環素類藥物為好,因為患者多數有淋球菌或其它合併感染。
(3)治療時間2-3周為宜。衣原體繁殖周期為48-72小時,寄生在細胞內,藥物滲入細胞內的濃度一般較低。所以治療時間需要長些。
(4)在男女感染後無症狀或症狀輕微者,可視為帶菌者,應接受正規治療。對患者的性伴要同時治療。
(5)聯合用藥:四環素類+嬌妍潔陰洗液+喹諾酮類+中藥婦炎丸
支原體和衣原體檢驗
支原體主要存在於人和動物的腔道黏膜。支原體生殖道感染與非淋菌性尿道炎或宮頸炎有關,此外可引起前列腺炎、附睪炎、輸卵管炎、流產、死產和不育症等。能引起人類非淋菌性尿道炎的主要有解脲支原體、人型支原體、生殖支原體。在正常人的泌尿生殖道中也可能有支原體寄生。
實驗室診斷主要採用液體分離培養和固體分離培養法
[原理]
解脲支原體(Uu)具有尿素酶,能分解尿素產氨,使含酚紅指示劑Uu液體培養基pH值升高變鹼性,液體顏色由黃變紅。
人型支原體(Mh)具有精氨酸酶,能分解精氨酸產氨,使含酚紅指示劑的Mh液體培養基pH值升高,液體顏色由黃變紅。
生殖支原體在含5%CO2環境中的固體培養基上,可形成煎蛋狀集落。但是,由於生殖支原體生長緩慢,而且需要的營養成分複雜,因此,分離培養的難度較大。目前主要靠DNA探針及PCR技術檢測生殖支原體。
[方法]
1.標本採集:
男性:用無菌棉拭子插入尿道約2cm處鏇轉,靜止數秒鐘後取材。女性:抹去宮頸口粘液,用無菌拭子插入宮頸管l-2cm鏇轉取材。
尚可用前列腺液、精液、尿液離心沉澱物作標本。
2.接種:將標本洗入Uu或Mh液體培養基,或用濾菌器過濾接種。
3.培養:置370C恆溫箱孵育1~3天,每日觀察培養基顏色變化。
[結果]
液體培養基由黃色變紅色,清亮透明可初步判斷為Uu或Mh陽性。
衣原體:專性細胞內寄生,並有近似的細胞壁結構,含DNA、RNA及核蛋白體,具有獨特生活周期的原核細胞型微生物。
衣原體的發育周期分為原體和始體兩個階段。原體具有傳染性,可在宿主細胞外存活,始體僅存在於細胞內無傳染性。能引起人類非淋菌性尿道炎的主要有沙眼衣原體。
實驗室診斷主要是衣原體抗原檢測(快速膠體金法)
[原理]
衣原體脂多糖抗原與膠體金標記的單克隆抗體結合形成複合物,複合物經虹吸作用而移動,在結果窗被含有的單克隆抗衣原體抗體捕獲而形成黑色沉澱線。
[方法]
1、取材:
男性:用無菌棉拭子插入尿道約2cm處鏇轉,靜止數秒鐘後取材。
女性:抹去宮頸口粘液,用無菌拭子插入宮頸管l-2cm鏇轉取材。
尚可用尿道取材、潰瘍部位或腹股溝橫痃抽吸液。
2、標本處理:將拭子置於採集管內加入提取緩衝液於刻度,800C水浴10分鐘,放置室溫冷卻至少5分鐘。
3、檢測:滴加5滴標本提取物於試驗板的檢測窗,靜置15分鐘,讀取結果。
[結果]
結果窗出現一條黑線,表明試驗陽性,如無,試驗陰性。
結果窗出現一弱黑線,表明結果可疑。
支原體衣原體病原體傳播途徑
非淋菌性尿道炎的傳染源是病人,主要通過性關係傳染,同其它性傳播疾病一樣,好發 於中青年性活躍時期,夫妻一方發病易感染另一方,感染衣原體、支原體的孕婦在分娩過程中可以感染新生兒。
傳播途徑:
①直接性 接觸感染,與患有非淋菌性尿道炎的病人性交時。
②間接接觸感染,使用患有非淋菌性尿道炎的病人用過的衣褲、床上用品、毛巾、 浴盆、抽水馬桶等。
③產道感染,患有非淋菌性尿道炎的產婦通過產道感染新生兒,另外婦產科醫生和母親的手指也是把病原體帶給 新生兒的一個重要途徑。在胎膜完整的情況下,從羊水、胎盤和胎兒血液中可分離出支原體,因而證明胎兒在宮內也可發生感染。